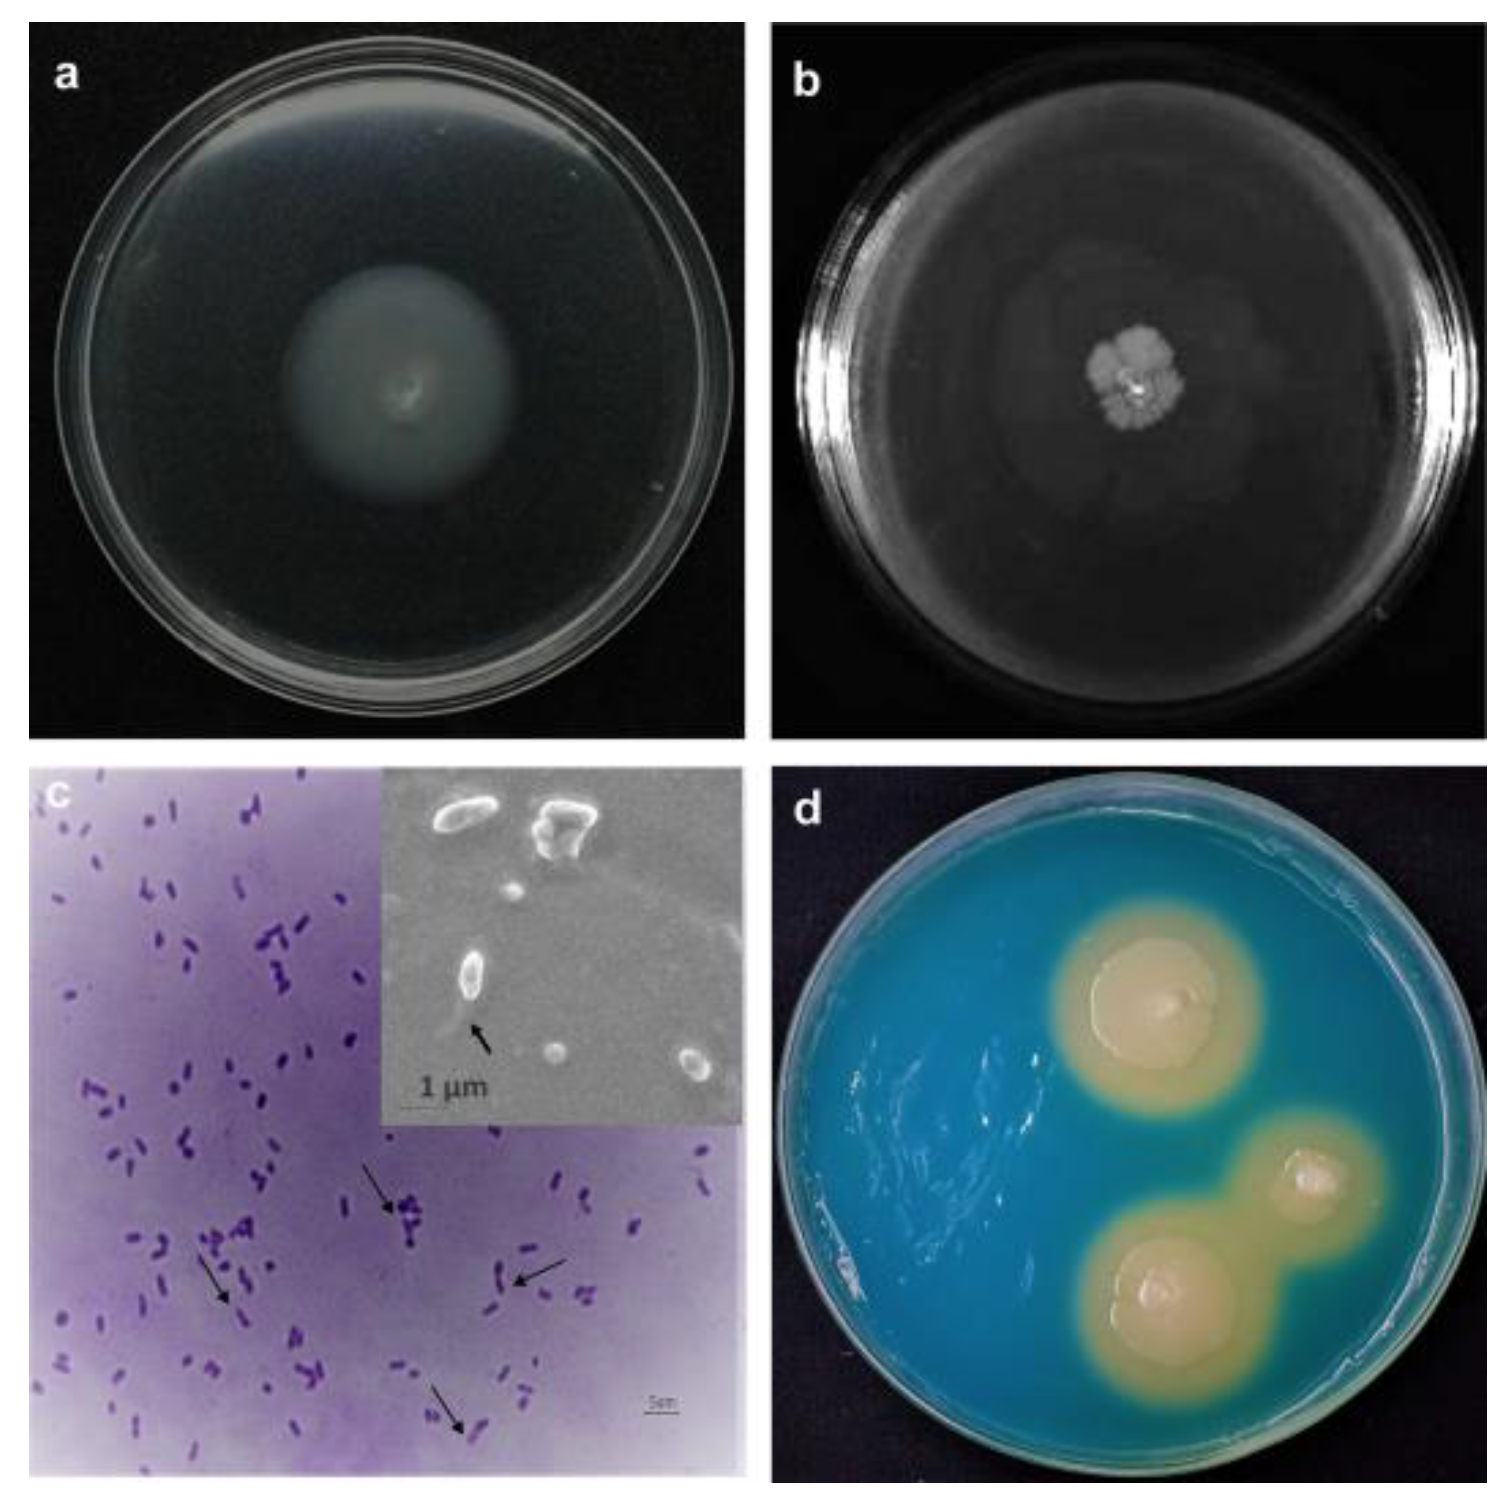

First Report of Pathogenic Bacterium Kalamiella piersonii Isolated from Urine of a Kidney Stone Patient: Draft Genome and Evidence for Role in Struvite Crystallization
Abstract
1. Introduction
2. Results
2.1. The Patient Demographics and Bacterial Characteristics
2.2. Taxonomic Identity and Draft Genome of Kalamiella piersonii YU22
2.3. Bacterial Adherence Factors, Motility and Biofilm Formation Involved in Virulence
2.3.1. Siderophore Production and Iron Uptake
2.3.2. Serum Killing, Host Cell Attachment and Cell Killing
2.4. Urea Metabolismin K. piersonii YU22
2.5. Amino Acid Catabolism, Ammonia Formation and Media pH
2.6. Growth in Synthetic Urine and Struvite Crystallization In Vitro Mediated by YU22
2.7. Antibiotic Susceptibility Pattern
3. Discussion
4. Methodology
4.1. Patient Sample and Bacterial Isolation
4.2. Biochemical and Physiological Analysis
4.3. 16S rRNA Gene Sequencing, Whole Genome Sequencing and Bioinformatics
4.4. Investigation on the Virulence Factors in YU22
4.5. In Vitro Assays for Host Cell Attachment and Cell Killing
4.6. Growth and Metabolic Activities of K. piersonii YU22 in Glucose, Urea, Amino Acids and in Urine
4.6.1. Colorimetric Determination of Metabolic Activity, Change in Media pH and NH4-N
4.6.2. Partition Plate Assay for Abiotic and Biotic Volatile NH3 Emission
4.7. In Vitro Struvite Crystallization Assays
4.8. Antibiogram of K. piersonii YU22
4.9. Data Analysis and Visualization Tools
4.10. Nucleotide Sequence Deposition and Data Availability
5. Conclusions
Supplementary Materials
Author Contributions
Funding
Acknowledgments
Conflicts of Interest
References
- Khan, S.R.; Pearle, M.S.; Robertson, W.G.; Gambaro, G.; Canales, B.K.; Doizi, S.; Traxer, O.; Tiselius, H.-G. Kidney stones. Nat. Rev. Dis. Prim. 2016, 2, 16008. [Google Scholar] [CrossRef]
- Alelign, T.; Petros, B. Kidney Stone Disease: An Update on Current Concepts. Adv. Urol. 2018, 2018, 1–12. [Google Scholar] [CrossRef]
- Flannigan, R.K.; Choy, W.H.; Chew, B.; Lange, D. Renal struvite stones—Pathogenesis, microbiology, and management strategies. Nat. Rev. Urol. 2014, 11, 333–341. [Google Scholar] [CrossRef]
- Thomas, B.; Tolley, D. Concurrent urinary tract infection and stone disease: Pathogenesis, diagnosis and management. Clin. Pract. Urol. 2008, 5, 668–675. [Google Scholar] [CrossRef]
- Flannigan, R.K.; Battison, A.; De, S.; Humphreys, M.R.; Bader, M.; Lellig, E.; Monga, M.; Chew, B.H.; Lange, D. Evaluating factors that dictate struvite stone composition: A multi-institutional clinical experience from the EDGE Research Consortium. Can. Urol. Assoc. J. 2018, 12, 131–136. [Google Scholar] [CrossRef] [PubMed]
- Schwaderer, A.L.; Wolfe, A.J. The association between bacteria and urinary stones. Ann. Transl. Med. 2017, 5, 32. [Google Scholar] [CrossRef] [PubMed]
- Justice, S.S.; Hung, C.; Theriot, J.A.; Fletcher, D.A.; Anderson, G.G.; Footer, M.J.; Hultgren, S.J. Differentiation and developmental pathways of uropathogenic Escherichia coli in urinary tract pathogenesis. Proc. Natl. Acad. Sci. USA 2004, 101, 1333–1338. [Google Scholar] [CrossRef] [PubMed]
- Andersen, T.E.; Khandige, S.; Madelung, M.; Brewer, J.R.; Kolmos, H.J.; Møller-Jensen, J. Escherichia coli Uropathogenesis In Vitro: Invasion, Cellular Escape, and Secondary Infection Analyzed in a Human Bladder Cell Infection Model. Infect. Immun. 2012, 80, 1858–1867. [Google Scholar] [CrossRef] [PubMed]
- Alteri, C.J.; Himpsl, S.D.; Shea, A.E.; Mobley, H.L.T. Flexible Metabolism and Suppression of Latent Enzymes Are Important for Escherichia coli Adaptation to Diverse Environments within the Host. J. Bacteriol. 2019, 201, e00181-19. [Google Scholar] [CrossRef]
- Jones, C.H.; Pinkner, J.S.; Roth, R.; Heuser, J.; Nicholes, A.V.; Abraham, S.N.; Hultgren, S.J. FimH adhesin of type 1 pili is assembled into a fibrillar tip structure in the Enterobacteriaceae. Proc. Natl. Acad. Sci. USA 1995, 92, 2081–2085. [Google Scholar] [CrossRef]
- Martinez, J.J.; Mulvey, M.; Schilling, J.D.; Pinkner, J.S.; Hultgren, S.J. Type 1 pilus-mediated bacterial invasion of bladder epithelial cells. EMBO J. 2000, 19, 2803–2812. [Google Scholar] [CrossRef] [PubMed]
- Mulvey, M. Adhesion and entry of uropathogenic Escherichia coli. Cell. Microbiol. 2002, 4, 257–271. [Google Scholar] [CrossRef] [PubMed]
- Singh, N.K.; Wood, J.M.; Mhatre, S.S.; Venkateswaran, K. Metagenome to phenome approach enables isolation and genomics characterization of Kalamiella piersonii gen. nov., sp. nov., from the international space station. Appl. Microbiol. Biotechnol. 2019, 103, 4487–4497. [Google Scholar] [CrossRef]
- Prod’Homme, M.; Micol, L.; Weitsch, S.; Gassend, J.-L.; Martinet, O.; Bellini, C. Cutaneous infection and bactaeremia caused by Erwinia billingiae: A case report. New Microbes New Infect. 2017, 19, 134–136. [Google Scholar] [CrossRef]
- Büyükçam, A.; Tuncer, Ö.; Gur, D.; Sancak, B.; Ceyhan, M.; Cengiz, A.B.; Kara, A. Clinical and microbiological characteristics of Pantoea agglomerans infection in children. J. Infect. Public Health 2018, 11, 304–309. [Google Scholar] [CrossRef]
- Palmer, M.; Steenkamp, E.T.; Coetzee, M.P.A.; Avontuur, J.R.; Chan, W.-Y.; Van Zyl, E.; Blom, J.; Venter, S. Mixta gen. nov., a new genus in the Erwiniaceae. Int. J. Syst. Evol. Microbiol. 2018, 68, 1396–1407. [Google Scholar] [CrossRef]
- Soutar, C.D.; Stavrinides, J. Molecular validation of clinical Pantoea isolates identified by MALDI-TOF. PLoS ONE 2019, 14, e0224731. [Google Scholar] [CrossRef]
- Strope, P.K.; Nickerson, K.W.; Harris, S.D.; Moriyama, E.N. Molecular evolution of urea amidolyase and urea carboxylase in fungi. BMC Evol. Boil. 2011, 11, 80. [Google Scholar] [CrossRef]
- Armbruster, C.E.; Hodges, S.A.; Mobley, H.L.T. Initiation of Swarming Motility by Proteus mirabilis Occurs in Response to Specific Cues Present in Urine and Requires Excess L-Glutamine. J. Bacteriol. 2013, 195, 1305–1319. [Google Scholar] [CrossRef]
- Lane, M.C.; Alteri, C.J.; Smith, S.N.; Mobley, H.L.T. Expression of flagella is coincident with uropathogenic Escherichia coli ascension to the upper urinary tract. Proc. Natl. Acad. Sci. USA 2007, 104, 16669–16674. [Google Scholar] [CrossRef]
- Wilson, B.R.; Bogdan, A.R.; Miyazawa, M.; Hashimoto, K.; Tsuji, Y. Siderophores in Iron Metabolism: From Mechanism to Therapy Potential. Trends Mol. Med. 2016, 22, 1077–1090. [Google Scholar] [CrossRef] [PubMed]
- Mann, R.; Mediati, D.G.; Duggin, I.G.; Harry, E.J.; Bottomley, A.L. Metabolic Adaptations of Uropathogenic E. coli in the Urinary Tract. Front. Cell. Infect. Microbiol. 2017, 7, 241. [Google Scholar] [CrossRef] [PubMed]
- Alteri, C.J.; Mobley, H.L.T. Metabolism and Fitness of Urinary Tract Pathogens. Microbiol. Spectr. 2015, 3. [Google Scholar] [CrossRef]
- Alteri, C.J.; Smith, S.N.; Mobley, H.L. Fitness of Escherichia coli during Urinary Tract Infection Requires Gluconeogenesis and the TCA Cycle. PLoS Pathog. 2009, 5, e1000448. [Google Scholar] [CrossRef]
- Kim, H.; Choi, J.; Kim, Y.; Kim, K.K. Crystal structure analysis of c4763, a uropathogenic Escherichia coli-specific protein. Acta Cryst. 2015, 71, 1042–1047. [Google Scholar] [CrossRef]
- Navarathna, D.H.M.L.P.; Lionakis, M.S.; Lizak, M.J.; Munasinghe, J.; Nickerson, K.W.; Roberts, D.D. Urea Amidolyase (DUR1,2) Contributes to Virulence and Kidney Pathogenesis of Candida albicans. PLoS ONE 2012, 7, e48475. [Google Scholar] [CrossRef]
- Izatulina, A.R.; Nikolaev, A.; Kuzmina, M.A.; Frank-Kamenetskaya, O.V.; Malyshev, V.V. Bacterial Effect on the Crystallization of Mineral Phases in a Solution Simulating Human Urine. Crystals 2019, 9, 259. [Google Scholar] [CrossRef]
- Brauer, A.L.; White, A.N.; Learman, B.S.; Johnson, A.O.; Armbruster, C.E. D-Serine Degradation by Proteus mirabilis Contributes to Fitness during Single-Species and Polymicrobial Catheter-Associated Urinary Tract Infection. MSphere 2019, 4, e00020-19. [Google Scholar] [CrossRef] [PubMed]
- Juarez, G.E.; Mateyca, C.; Galvan, E.M. Proteus mirabilis outcompetes Klebsiella pneumoniae in artificial urine medium through secretion of ammonia and other volatile compounds. Heliyon 2020, 6, e03361. [Google Scholar] [CrossRef]
- Bichler, K.-H.; Eipper, E.; Naber, K.; Braun, V.; Zimmermann, R.; Lahme, S. Urinary infection stones. Int. J. Antimicrob. Agents 2002, 19, 488–498. [Google Scholar] [CrossRef]
- Bhadra, B.; Roy, P.; Chakraborty, R. Serratia ureilytica sp. nov., a novel urea-utilizing species. Int. J. Syst. Evol. Microbiol. 2005, 55, 2155–2158. [Google Scholar] [CrossRef] [PubMed]
- Rivadeneyra, M.A.; Gutierrez-Calderón, A.; Rivadeneyra, A.M.; Ramos-Cormenzana, A. A study of struvite precipitation and urease activity in bacteria isolated from patients with urinary infections and their possible involvement in the formation of renal calculi. Urol. Int. 1999, 63, 188–192. [Google Scholar] [CrossRef] [PubMed]
- Rivadeneyra, M.A.; Calvo, C.; González-Torres, M.C.; Perez-García, I.; Ramos-Cormenzana, A. Precipitation of Struvite in Urine Medium by Urease-Positive and Urease-Negative Yersinia Strains. Urol. Int. 1990, 45, 298–301. [Google Scholar] [CrossRef] [PubMed]
- Parkhomenko, E.; De Fazio, A.; Tran, T.; Thai, J.; Blum, K.; Gupta, M. A Multi-Institutional Study of Struvite Stones: Patterns of Infection and Colonization. J. Endourol. 2017, 31, 533–537. [Google Scholar] [CrossRef] [PubMed]
- Griffith, D.P.; Musher, D.M.; Itin, C. Urease. The primary cause of infection-induced urinary stones. Investig. Urol. 1976, 13, 346–450. [Google Scholar] [CrossRef]
- Rivadeneyra, M.A.; Pérez-García, I.; Ramos-Cormenzana, A. Influence of ammonium ion on bacterial struvite production. Geomicrobiol. J. 1992, 10, 125–137. [Google Scholar] [CrossRef]
- Yoon, S.-H.; Ha, S.-M.; Kwon, S.; Lim, J.; Kim, Y.; Seo, H.; Chun, J. Introducing EzBioCloud: A taxonomically united database of 16S rRNA gene sequences and whole-genome assemblies. Int. J. Syst. Evol. Microbiol. 2017, 67, 1613–1617. [Google Scholar] [CrossRef]
- Nurk, S.; Bankevich, A.; Antipov, D.; Gurevich, A.A.; Korobeynikov, A.; Lapidus, A.; Prjibelski, A.D.; Pyshkin, A.; Sirotkin, A.; Sirotkin, Y.; et al. Assembling Single-Cell Genomes and Mini-Metagenomes From Chimeric MDA Products. J. Comput. Boil. 2013, 20, 714–737. [Google Scholar] [CrossRef]
- Lee, I.; Kim, Y.O.; Park, S.-C.; Chun, J. OrthoANI: An improved algorithm and software for calculating average nucleotide identity. Int. J. Syst. Evol. Microbiol. 2016, 66, 1100–1103. [Google Scholar] [CrossRef]
- Aziz, R.K.; Bartels, D.; Best, A.A.; DeJongh, M.; Disz, T.; Edwards, R.A.; Formsma, K.; Gerdes, S.Y.; Glass, E.; Kubal, M.; et al. The RAST Server: Rapid Annotations using Subsystems Technology. BMC Genom. 2008, 9, 75. [Google Scholar] [CrossRef]
- Thompson, J.D.; Gibson, T.J.; Plewniak, F.; Jeanmougin, F.; Higgins, D.G. The CLUSTAL_X windows interface: Flexible strategies for multiple sequence alignment aided by quality analysis tools. Nucleic Acids Res. 1997, 25, 4876–4882. [Google Scholar] [CrossRef] [PubMed]
- Tamura, K.; Peterson, D.; Peterson, N.; Stecher, G.; Nei, M.; Kumar, S. MEGA5: Molecular Evolutionary Genetics Analysis Using Maximum Likelihood, Evolutionary Distance, and Maximum Parsimony Methods. Mol. Boil. Evol. 2011, 28, 2731–2739. [Google Scholar] [CrossRef] [PubMed]
- Felsenstein, J. Evolutionary trees from DNA sequences: A maximum likelihood approach. J. Mol. Evol. 1981, 17, 368–376. [Google Scholar] [CrossRef] [PubMed]
- Felsenstein, J. Confidence Limits on Phylogenies: An Approach Using the Bootstrap. Evolution 1985, 39, 783–791. [Google Scholar] [CrossRef] [PubMed]
- Ha, D.-G.; Kuchma, S.L.; O’Toole, G.A. Plate-Based Assay for Swimming Motility in Pseudomonas aeruginosa. In Pseudomonas Methods and Protocols; Humana Press: New York, NY, USA, 2014; pp. 59–65. [Google Scholar] [CrossRef]
- Rashid, M.H.; Kornberg, A. Inorganic polyphosphate is needed for swimming, swarming, and twitching motilities of Pseudomonas aeruginosa. Proc. Natl. Acad. Sci. USA 2000, 97, 4885–4890. [Google Scholar] [CrossRef] [PubMed]
- Kodaka, H.; Armfield, A.Y.; Lombard, G.L.; Dowell, V.R. Practical procedure for demonstrating bacterial flagella. J. Clin. Microbiol. 1982, 16, 948–952. [Google Scholar] [CrossRef]
- Stepanović, S.; Vuković, D.; Dakić, I.; Savić, B.; Švabić-Vlahović, M. A modified microtiter-plate test for quantification of staphylococcal biofilm formation. J. Microbiol. Methods 2000, 40, 175–179. [Google Scholar] [CrossRef]
- Schwyn, B.; Neilands, J. Universal chemical assay for the detection and determination of siderophores. Anal. Biochem. 1987, 160, 47–56. [Google Scholar] [CrossRef]
- Vipin, C.; Mujeeburahiman, M.; Ashwini, P.; Arun, A.; Rekha, P.D.; Chembili, V.; Prabhu, A.; Bhagwath, A.A.; Punchappady-Devasya, R. Anti-biofilm and cytoprotective activities of quercetin against Pseudomonas aeruginosa isolates. Lett. Appl. Microbiol. 2019, 68, 464–471. [Google Scholar] [CrossRef]
- Baethgen, W.E.; Alley, M.M. A manual colorimetric procedure for measuring ammonium nitrogen in soil and plant Kjeldahl digests. Commun. Soil Sci. Plant Anal. 1989, 20, 961–969. [Google Scholar] [CrossRef]
- Manzoor, M.A.P.; Singh, B.; Agrawal, A.K.; Arun, A.B.; Mujeeburahiman, M.; Rekha, P.D. Morphological and micro-tomographic study on evolution of struvite in synthetic urine infected with bacteria and investigation of its pathological biomineralization. PLoS ONE 2018, 13, e0202306. [Google Scholar] [CrossRef] [PubMed]
- Mulready, K.J.; McGoldrick, D. The establishment of a standard and real patient kidney stone library utilizing Fourier transform-infrared spectroscopy with a diamond ATR accessory. Urol. Res. 2012, 40, 483–498. [Google Scholar] [CrossRef] [PubMed]
- Clinical and Laboratory Standards Institute (CLSI). Performance Standards for Antimicrobial Susceptibility Testing; 20th Informational supplement M100-S20; CLSI: Wayne, NE, USA, 2010. [Google Scholar]
- Alikhan, N.-F.; Petty, N.K.; Ben Zakour, N.L.; Beatson, S.A. BLAST Ring Image Generator (BRIG): Simple prokaryote genome comparisons. BMC Genom. 2011, 12, 402. [Google Scholar] [CrossRef] [PubMed]
- Tatusov, R.L.; Galperin, M.Y.; Natale, D.A.; Koonin, E.V. The COG database: A tool for genome-scale analysis of protein functions and evolution. Nucleic Acids Res. 2000, 28, 33–36. [Google Scholar] [CrossRef]
- Wu, S.; Zhu, Z.; Fu, L.; Niu, B.; Li, W. WebMGA: A customizable web server for fast metagenomic sequence analysis. BMC Genom. 2011, 12, 444. [Google Scholar] [CrossRef]
- Marchler-Bauer, A.; Derbyshire, M.K.; Gonzales, N.R.; Lu, S.; Chitsaz, F.; Geer, L.Y.; Geer, R.C.; He, J.; Gwadz, M.; Hurwitz, D.I.; et al. CDD: NCBI’s conserved domain database. Nucleic Acids Res. 2014, 43, D222–D226. [Google Scholar] [CrossRef]
- Overbeek, R.; Olson, R.; Pusch, G.D.; Olsen, G.J.; Davis, J.J.; Disz, T.; Edwards, R.A.; Gerdes, S.; Parrello, B.; Shukla, M.; et al. The SEED and the Rapid Annotation of microbial genomes using Subsystems Technology (RAST). Nucleic Acids Res. 2014, 42, D206–D214. [Google Scholar] [CrossRef]

| Assignments | Reported IR Frequencies Wave Numbers (cm−1) | Observed IR Frequencies Wavenumbers (cm−1) | |
|---|---|---|---|
| Biotic (YU22) | Abiotic | ||
| Absorption peak due to water of crystallization | |||
| H-O-H stretching vibrations of H2O of crystallization | 3280 to 3550 | 3316 | 3550 |
| H-O-H stretching vibrations of cluster of water molecules of crystallization | 2060 to 2460 | 2206 | 2298 |
| H-O-H bending modes of vibrations | 1590 to 1650 | 1652 | 1622 |
| Vagging modes of vibration of coordinated water | 808 | 778 | 808 |
| Absorption peak due to PO4 units | |||
| V1 symmetric stretching vibration | 930 to 995 | 995 | 988 |
| V2 symmetric bending vibration | 404 to 470 | 471 | 404, 455 |
| V3 asymmetric bending vibration | 1017 to 1163 | 1015, 1018 | 1018, 1164 |
| V4 asymmetric bending modes | 509 to 554 | 544 | 510, 555 |
| Metal-oxygen bonds | |||
| Metal-oxygen bonds | 400–650 | 460 | 651 |
| Deformation of OH linked to Mg2+ | 847 | 847 | 847 |
| Antibiotic | Sensitivity | Antibiotic | Sensitivity |
|---|---|---|---|
| Levofloxacin (5 µg) | S | Collistin (10 µg) | S |
| Merophenem (10 µg) | S | Tetracycline (30 µg) | S |
| Imipenem (10 µg) | S | Aztreonam (30 µg) | I |
| Co-trimoxozole (25 µg) | S | Ampicillin (10 µg) | R |
| Tobramycin (10 µg) | S | Ceftazidime (30 µg) | R |
| Ciprofloxacin (5 µg) | S | Penicillin–G (10 units) | R |
| Clindamycin (10 µg) | S | Vancomycin (30 µg) | R |
| Amikacin (30 µg) | S | Piperacillin (100 µg) | R |
| Gentamicin (10 µg) | S | Rifampicin (5 µg) | R |
© 2020 by the authors. Licensee MDPI, Basel, Switzerland. This article is an open access article distributed under the terms and conditions of the Creative Commons Attribution (CC BY) license (http://creativecommons.org/licenses/by/4.0/).
Share and Cite
Rekha, P.D.; Hameed, A.; Manzoor, M.A.P.; Suryavanshi, M.V.; Ghate, S.D.; Arun, A.B.; Rao, S.S.; Athmika; Bajire, S.K.; Mujeeburahiman, M.; et al. First Report of Pathogenic Bacterium Kalamiella piersonii Isolated from Urine of a Kidney Stone Patient: Draft Genome and Evidence for Role in Struvite Crystallization. Pathogens 2020, 9, 711. https://doi.org/10.3390/pathogens9090711
Rekha PD, Hameed A, Manzoor MAP, Suryavanshi MV, Ghate SD, Arun AB, Rao SS, Athmika, Bajire SK, Mujeeburahiman M, et al. First Report of Pathogenic Bacterium Kalamiella piersonii Isolated from Urine of a Kidney Stone Patient: Draft Genome and Evidence for Role in Struvite Crystallization. Pathogens. 2020; 9(9):711. https://doi.org/10.3390/pathogens9090711
Chicago/Turabian StyleRekha, Punchappady Devasya, Asif Hameed, Muhammed A. P. Manzoor, Mangesh V. Suryavanshi, Sudeep D. Ghate, A. B. Arun, Sneha S. Rao, Athmika, Sukesh Kumar Bajire, M. Mujeeburahiman, and et al. 2020. "First Report of Pathogenic Bacterium Kalamiella piersonii Isolated from Urine of a Kidney Stone Patient: Draft Genome and Evidence for Role in Struvite Crystallization" Pathogens 9, no. 9: 711. https://doi.org/10.3390/pathogens9090711
APA StyleRekha, P. D., Hameed, A., Manzoor, M. A. P., Suryavanshi, M. V., Ghate, S. D., Arun, A. B., Rao, S. S., Athmika, Bajire, S. K., Mujeeburahiman, M., & Young, C.-C. (2020). First Report of Pathogenic Bacterium Kalamiella piersonii Isolated from Urine of a Kidney Stone Patient: Draft Genome and Evidence for Role in Struvite Crystallization. Pathogens, 9(9), 711. https://doi.org/10.3390/pathogens9090711

